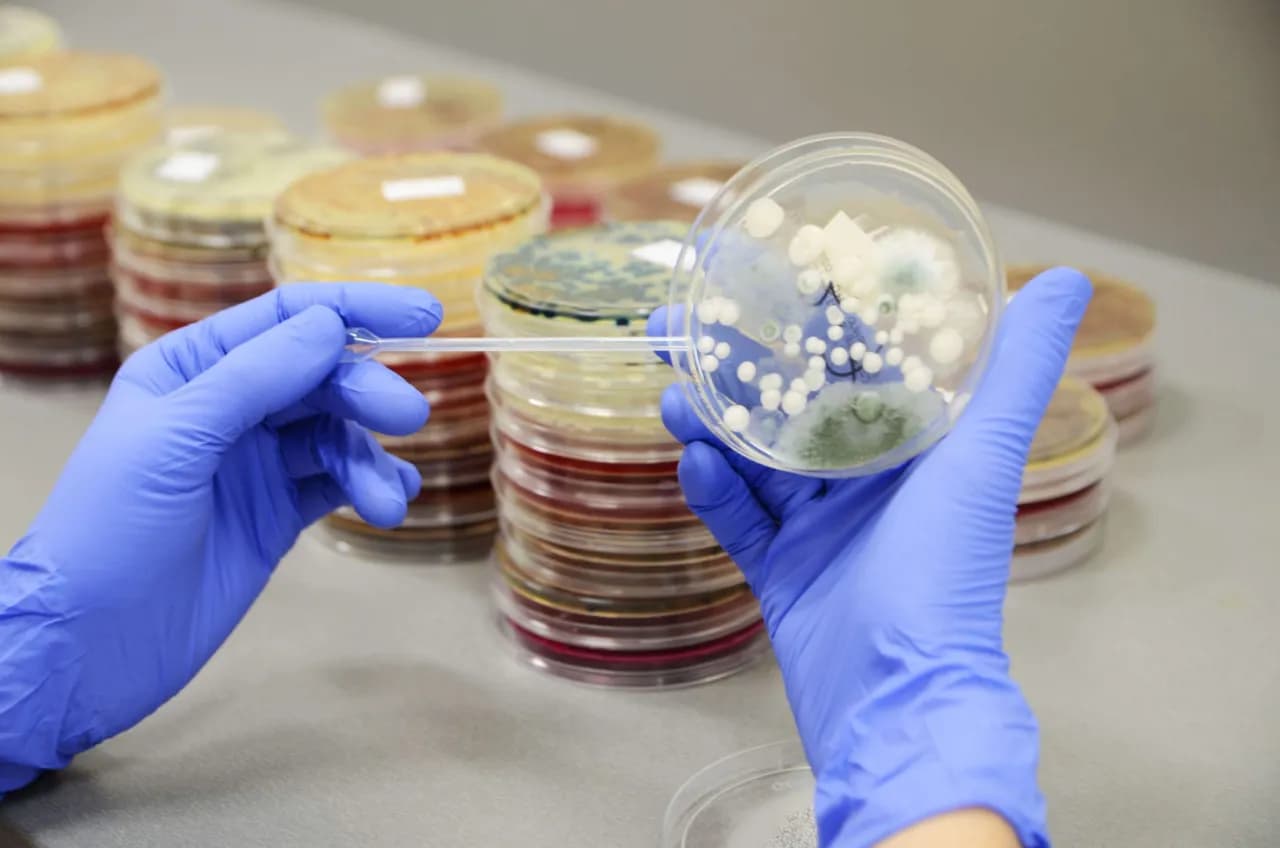

Grzybica jelit, znana również jako kandydoza jelitowa, to schorzenie wywołane przez nadmierny rozrost drożdżaków z rodzaju Candida. Wiele osób może nie zdawać sobie sprawy, że te grzyby, które naturalnie występują w organizmie, mogą stać się problemem zdrowotnym, gdy ich ilość wymknie się spod kontroli. Aby zdiagnozować tę chorobę, lekarze stosują różne badania, w tym badania kału oraz testy serologiczne, które pomagają ocenić obecność grzybów i ich wpływ na zdrowie pacjenta.
W niniejszym artykule przyjrzymy się kluczowym badaniom, które są niezbędne do postawienia diagnozy grzybicy jelit. Zrozumienie objawów, przyczyn oraz metod leczenia kandydozy jelitowej pomoże w skuteczniejszym zarządzaniu tym schorzeniem i poprawie jakości życia pacjentów.
Kluczowe informacje:- Grzybica jelit jest spowodowana nadmiernym rozrostem grzybów Candida.
- Do diagnozy stosuje się badania kału, które oceniają obecność grzybów.
- Testy serologiczne pomagają potwierdzić diagnozę kandydozy.
- Objawy grzybicy jelit mogą obejmować problemy żołądkowo-jelitowe oraz ogólne osłabienie.
- Czynniki ryzyka to m.in. stosowanie antybiotyków oraz osłabiony układ odpornościowy.
- Dieta i styl życia mają znaczący wpływ na rozwój grzybicy jelit.
- Leczenie może obejmować farmakoterapię oraz naturalne metody wsparcia.
Jakie badania są kluczowe w diagnozie grzybicy jelit?
W diagnozie grzybicy jelit kluczowe jest przeprowadzenie odpowiednich badań, które pozwalają na potwierdzenie obecności grzybów z rodzaju Candida. Najczęściej stosowanymi metodami są badania kału oraz testy serologiczne. Obie te metody mają swoje unikalne znaczenie i mogą dostarczyć cennych informacji na temat stanu zdrowia pacjenta.
Badania te są niezbędne do określenia, czy pacjent rzeczywiście zmaga się z kandydozą jelitową. Odpowiednia diagnoza jest kluczowa, aby móc wdrożyć skuteczne leczenie. W kolejnych podsekcjach przyjrzymy się bliżej każdemu z tych badań, ich procedurom oraz znaczeniu w procesie diagnostycznym.
Badania kału na obecność grzybów Candida i ich znaczenie
Badanie kału to jedna z podstawowych metod diagnozowania grzybicy jelit. W trakcie tego badania próbka stolca jest analizowana w laboratorium w celu wykrycia obecności grzybów Candida. Proces ten polega na pobraniu próbki kału, która następnie jest badana pod kątem obecności grzybów i ich metabolitów. Wyniki tego badania pozwalają na ocenę, czy pacjent ma nadmierny wzrost tych drożdżaków w jelitach.
Testy serologiczne i ich rola w diagnozie kandydozy
Testy serologiczne to kolejna ważna metoda diagnozowania grzybicy jelit. Te badania polegają na analizie krwi pacjenta w celu wykrycia przeciwciał przeciwko grzybom Candida. W przeciwieństwie do badań kału, testy serologiczne mogą dostarczyć informacji o odpowiedzi immunologicznej organizmu na infekcję. Dzięki nim lekarze mogą potwierdzić diagnozę oraz ocenić stopień zaawansowania choroby.
Objawy grzybicy jelit, które mogą wskazywać na potrzebę badań
Grzybica jelit, znana również jako kandydoza jelitowa, może objawiać się różnorodnymi symptomami, które często są mylone z innymi dolegliwościami. W przypadku nadmiernego rozrostu drożdżaków Candida, pacjenci mogą doświadczać takich objawów jak bóle brzucha, wzdęcia, czy zmiany w rytmie wypróżnień. Zrozumienie tych symptomów jest kluczowe, ponieważ mogą one wskazywać na konieczność przeprowadzenia odpowiednich badań diagnostycznych.
Objawy grzybicy jelit mogą być zarówno gastrointestinalne, jak i systemowe. Często pacjenci skarżą się na chroniczne zmęczenie, problemy ze skórą, a nawet depresję. Takie objawy mogą świadczyć o tym, że organizm boryka się z nadmiernym rozrostem grzybów, co powinno skłonić do konsultacji z lekarzem i wykonania odpowiednich testów. W kolejnej sekcji przyjrzymy się bardziej szczegółowo typowym objawom, które warto znać.
Typowe objawy grzybicy jelit, które warto znać
Wśród typowych objawów grzybicy jelit można wymienić kilka, które powinny wzbudzić czujność pacjentów. Należą do nich: biegunka, zapalenie jelita, oraz wzdęcia. Osoby z kandydozą jelitową często skarżą się także na uczucie pełności oraz dyskomfort w obrębie brzucha. Zmiany te mogą prowadzić do poważnych komplikacji, dlatego warto zwracać uwagę na te sygnały i nie bagatelizować ich.
- Biegunka – może być wynikiem zaburzeń flory bakteryjnej w jelitach.
- Wzdęcia – często towarzyszą problemom trawiennym związanym z grzybicą.
- Chroniczne zmęczenie – może być wynikiem ogólnego osłabienia organizmu.
Jak różnicować objawy grzybicy jelit od innych schorzeń
Różnicowanie objawów grzybicy jelit od innych schorzeń jest kluczowe dla postawienia prawidłowej diagnozy. Objawy kandydozy jelitowej, takie jak bóle brzucha, wzdęcia czy biegunka, mogą być mylone z innymi dolegliwościami, takimi jak zespół jelita drażliwego czy nietolerancje pokarmowe. Ważne jest, aby lekarz przeanalizował pełen obraz kliniczny pacjenta, uwzględniając historię chorób oraz dodatkowe objawy, które mogą wskazywać na inne schorzenia.
W diagnostyce różnicowej istotne jest również zrozumienie, że objawy kandydozy mogą występować w połączeniu z innymi problemami zdrowotnymi, takimi jak choroby autoimmunologiczne czy zaburzenia równowagi flory bakteryjnej. Dlatego lekarze często zalecają wykonanie dodatkowych badań, aby wykluczyć inne potencjalne przyczyny dolegliwości. Właściwa diagnoza jest kluczowa, aby móc skutecznie leczyć i zarządzać stanem zdrowia pacjenta.Czynniki ryzyka sprzyjające rozwojowi kandydozy jelitowej
Istnieje wiele czynników ryzyka, które mogą zwiększać prawdopodobieństwo rozwoju grzybicy jelit. Jednym z najważniejszych jest stosowanie antybiotyków, które mogą zaburzać naturalną florę bakteryjną jelit, prowadząc do nadmiernego wzrostu drożdżaków Candida. Osoby z osłabionym układem odpornościowym, na przykład z HIV/AIDS lub po przeszczepach, również są bardziej narażone na rozwój kandydozy. Dodatkowo, osoby z przewlekłymi chorobami, takimi jak cukrzyca, mogą mieć większe ryzyko wystąpienia tej infekcji.
Innymi czynnikami ryzyka są stres, który wpływa na funkcjonowanie układu odpornościowego, oraz dieta bogata w cukry i przetworzone produkty, co sprzyja rozwojowi grzybów. Warto także zwrócić uwagę na zmiany hormonalne, które mogą występować w czasie ciąży lub podczas stosowania hormonalnej terapii zastępczej. Zrozumienie tych czynników ryzyka jest kluczowe, aby móc skutecznie zapobiegać rozwojowi grzybicy jelit.Jak dieta i styl życia wpływają na rozwój grzybicy jelit
Dieta oraz styl życia odgrywają istotną rolę w rozwoju grzybicy jelit. Spożywanie dużych ilości cukrów prostych, białego pieczywa oraz przetworzonych produktów może sprzyjać rozwojowi drożdżaków Candida. Warto dbać o zrównoważoną dietę, bogatą w błonnik, warzywa, owoce oraz produkty pełnoziarniste, które wspierają zdrową florę bakteryjną jelit. Regularne spożywanie probiotyków, na przykład jogurtów naturalnych, może pomóc w utrzymaniu równowagi mikrobiomu jelitowego.
Styl życia również ma znaczenie — regularna aktywność fizyczna, odpowiednia ilość snu oraz unikanie stresu mogą przyczynić się do lepszego funkcjonowania układu odpornościowego. Należy również pamiętać o odpowiednim nawodnieniu organizmu. Wprowadzenie tych zdrowych nawyków może pomóc w zapobieganiu rozwojowi kandydozy jelit.Czytaj więcej: Co to jest badanie cito i dlaczego jego szybkość ma znaczenie?
Opcje leczenia grzybicy jelit po postawieniu diagnozy
Po postawieniu diagnozy grzybicy jelit, istnieje wiele opcji leczenia, które mogą pomóc w przywróceniu równowagi mikrobiologicznej w jelitach. Wśród najczęściej stosowanych metod są zarówno terapie farmakologiczne, jak i naturalne metody wsparcia. Wybór odpowiedniego podejścia zależy od stopnia zaawansowania choroby oraz indywidualnych potrzeb pacjenta.
Farmakoterapia zazwyczaj obejmuje stosowanie leków przeciwgrzybiczych, które mają na celu eliminację drożdżaków Candida z organizmu. Naturalne metody wsparcia mogą obejmować zmiany w diecie oraz suplementację, co wspiera proces leczenia i poprawia ogólny stan zdrowia pacjenta. W dalszej części omówimy szczegółowo te dwa podejścia do leczenia.
Farmakoterapia w leczeniu kandydozy jelitowej
W leczeniu kandydozy jelitowej najczęściej stosuje się leki przeciwgrzybicze, takie jak flukonazol i itrakonazol. Flukonazol jest popularnym wyborem, ponieważ jest skuteczny w eliminowaniu grzybów z organizmu i ma stosunkowo niewiele działań niepożądanych. Itrakonazol natomiast, jest często stosowany w przypadku bardziej opornych infekcji. Leczenie farmakologiczne powinno być prowadzone pod kontrolą lekarza, aby zminimalizować ryzyko wystąpienia działań niepożądanych oraz zapewnić skuteczność terapii.
Naturalne metody wsparcia w terapii grzybicy jelit
Oprócz farmakoterapii, wiele osób decyduje się na naturalne metody wsparcia, które mogą być pomocne w leczeniu grzybicy jelit. Do popularnych suplementów należą probiotyki, które wspierają zdrową florę bakteryjną i pomagają w walce z drożdżakami. Również czosnek i olej z oregano są znane ze swoich właściwości przeciwgrzybiczych. Warto jednak pamiętać, że naturalne metody nie zastępują leczenia farmakologicznego, ale mogą być skutecznym uzupełnieniem terapii. Wprowadzenie zdrowych nawyków żywieniowych oraz regularna aktywność fizyczna również przyczyniają się do poprawy stanu zdrowia.
| Naturalny środek | Korzyści | Potencjalne skutki uboczne |
| Probiotyki | Wspierają równowagę flory jelitowej | Możliwe wzdęcia |
| Czosnek | Ma właściwości przeciwgrzybicze | Może powodować nieprzyjemny zapach |
| Olej z oregano | Skuteczny w eliminacji drożdżaków | Może podrażniać błonę śluzową żołądka |
Jak wprowadzenie zdrowych nawyków może wspierać leczenie grzybicy jelit
Wprowadzenie zdrowych nawyków żywieniowych i stylu życia może znacząco wspierać proces leczenia grzybicy jelit. Oprócz stosowania leków przeciwgrzybiczych i suplementów, warto skupić się na eliminacji czynników wywołujących nadmierny wzrost drożdżaków Candida. Przykładem może być wprowadzenie diety eliminacyjnej, która na pewien czas wyklucza produkty bogate w cukry oraz przetworzone węglowodany, co pozwala na regenerację flory jelitowej. Dodatkowo, regularne spożywanie pokarmów bogatych w błonnik, jak warzywa, owoce i pełnoziarniste zboża, może pomóc w utrzymaniu zdrowego mikrobiomu.
Warto również rozważyć techniki redukcji stresu, takie jak medytacja, joga czy techniki oddechowe, które mogą wspierać układ odpornościowy i zmniejszać ryzyko nawrotów kandydozy. W przyszłości, zrozumienie indywidualnych potrzeb organizmu poprzez testy genetyczne i mikrobiomowe może prowadzić do bardziej spersonalizowanych strategii leczenia, co zwiększy efektywność terapii i poprawi jakość życia pacjentów z grzybicą jelit.